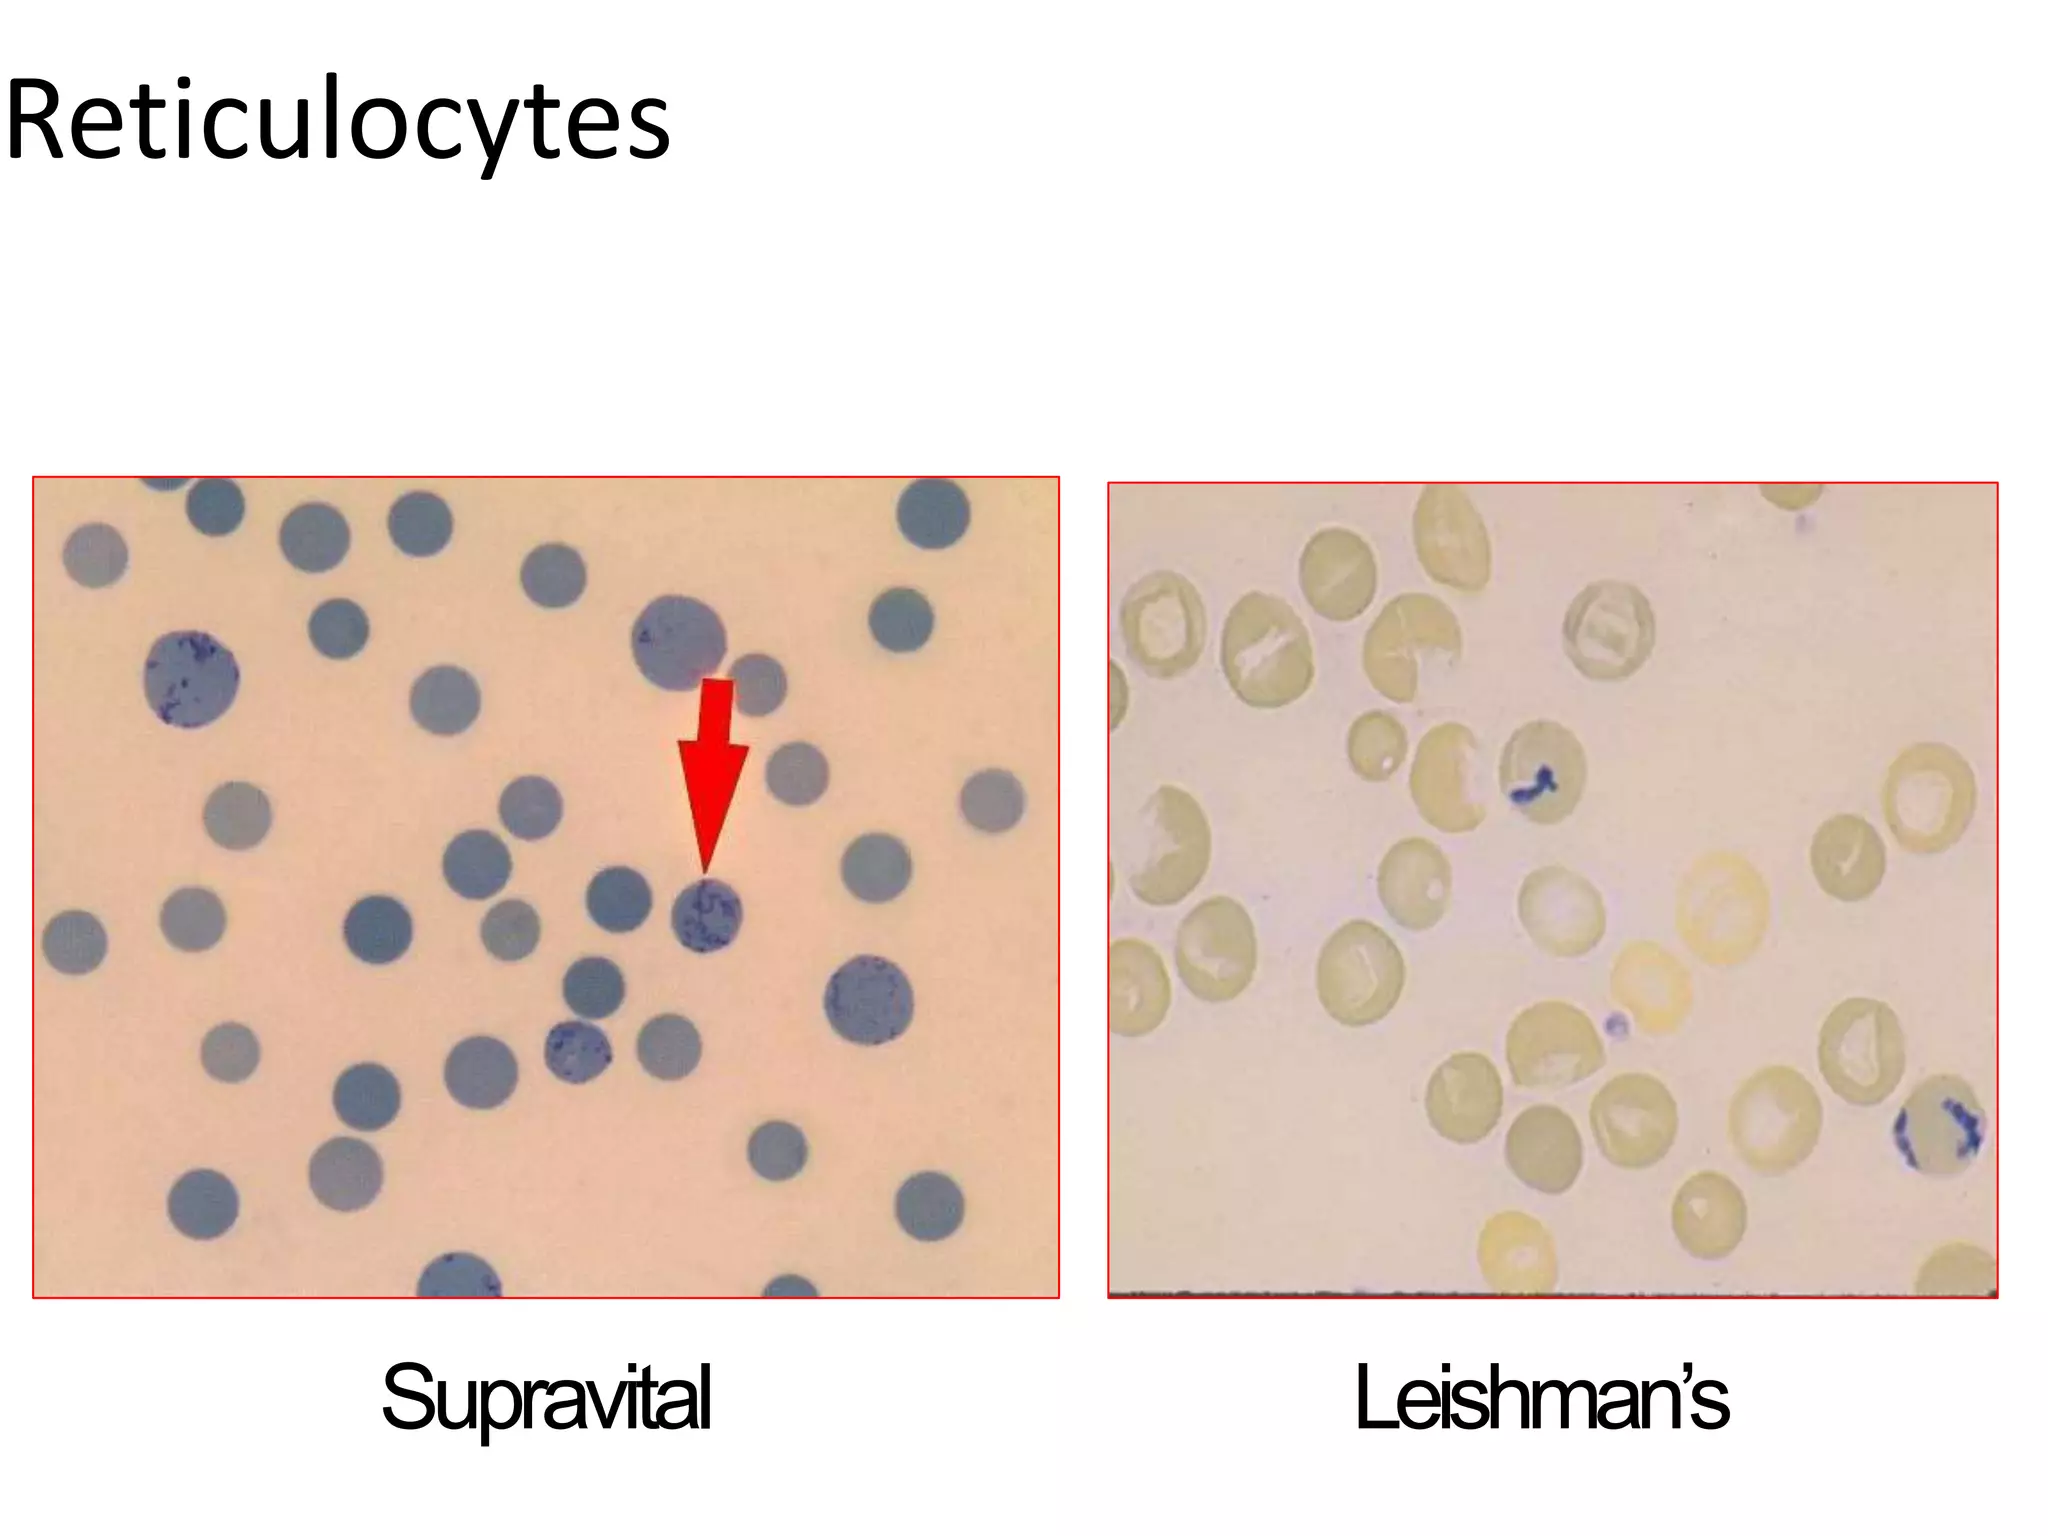
Reticulocytes
Leishman’s
Supravital
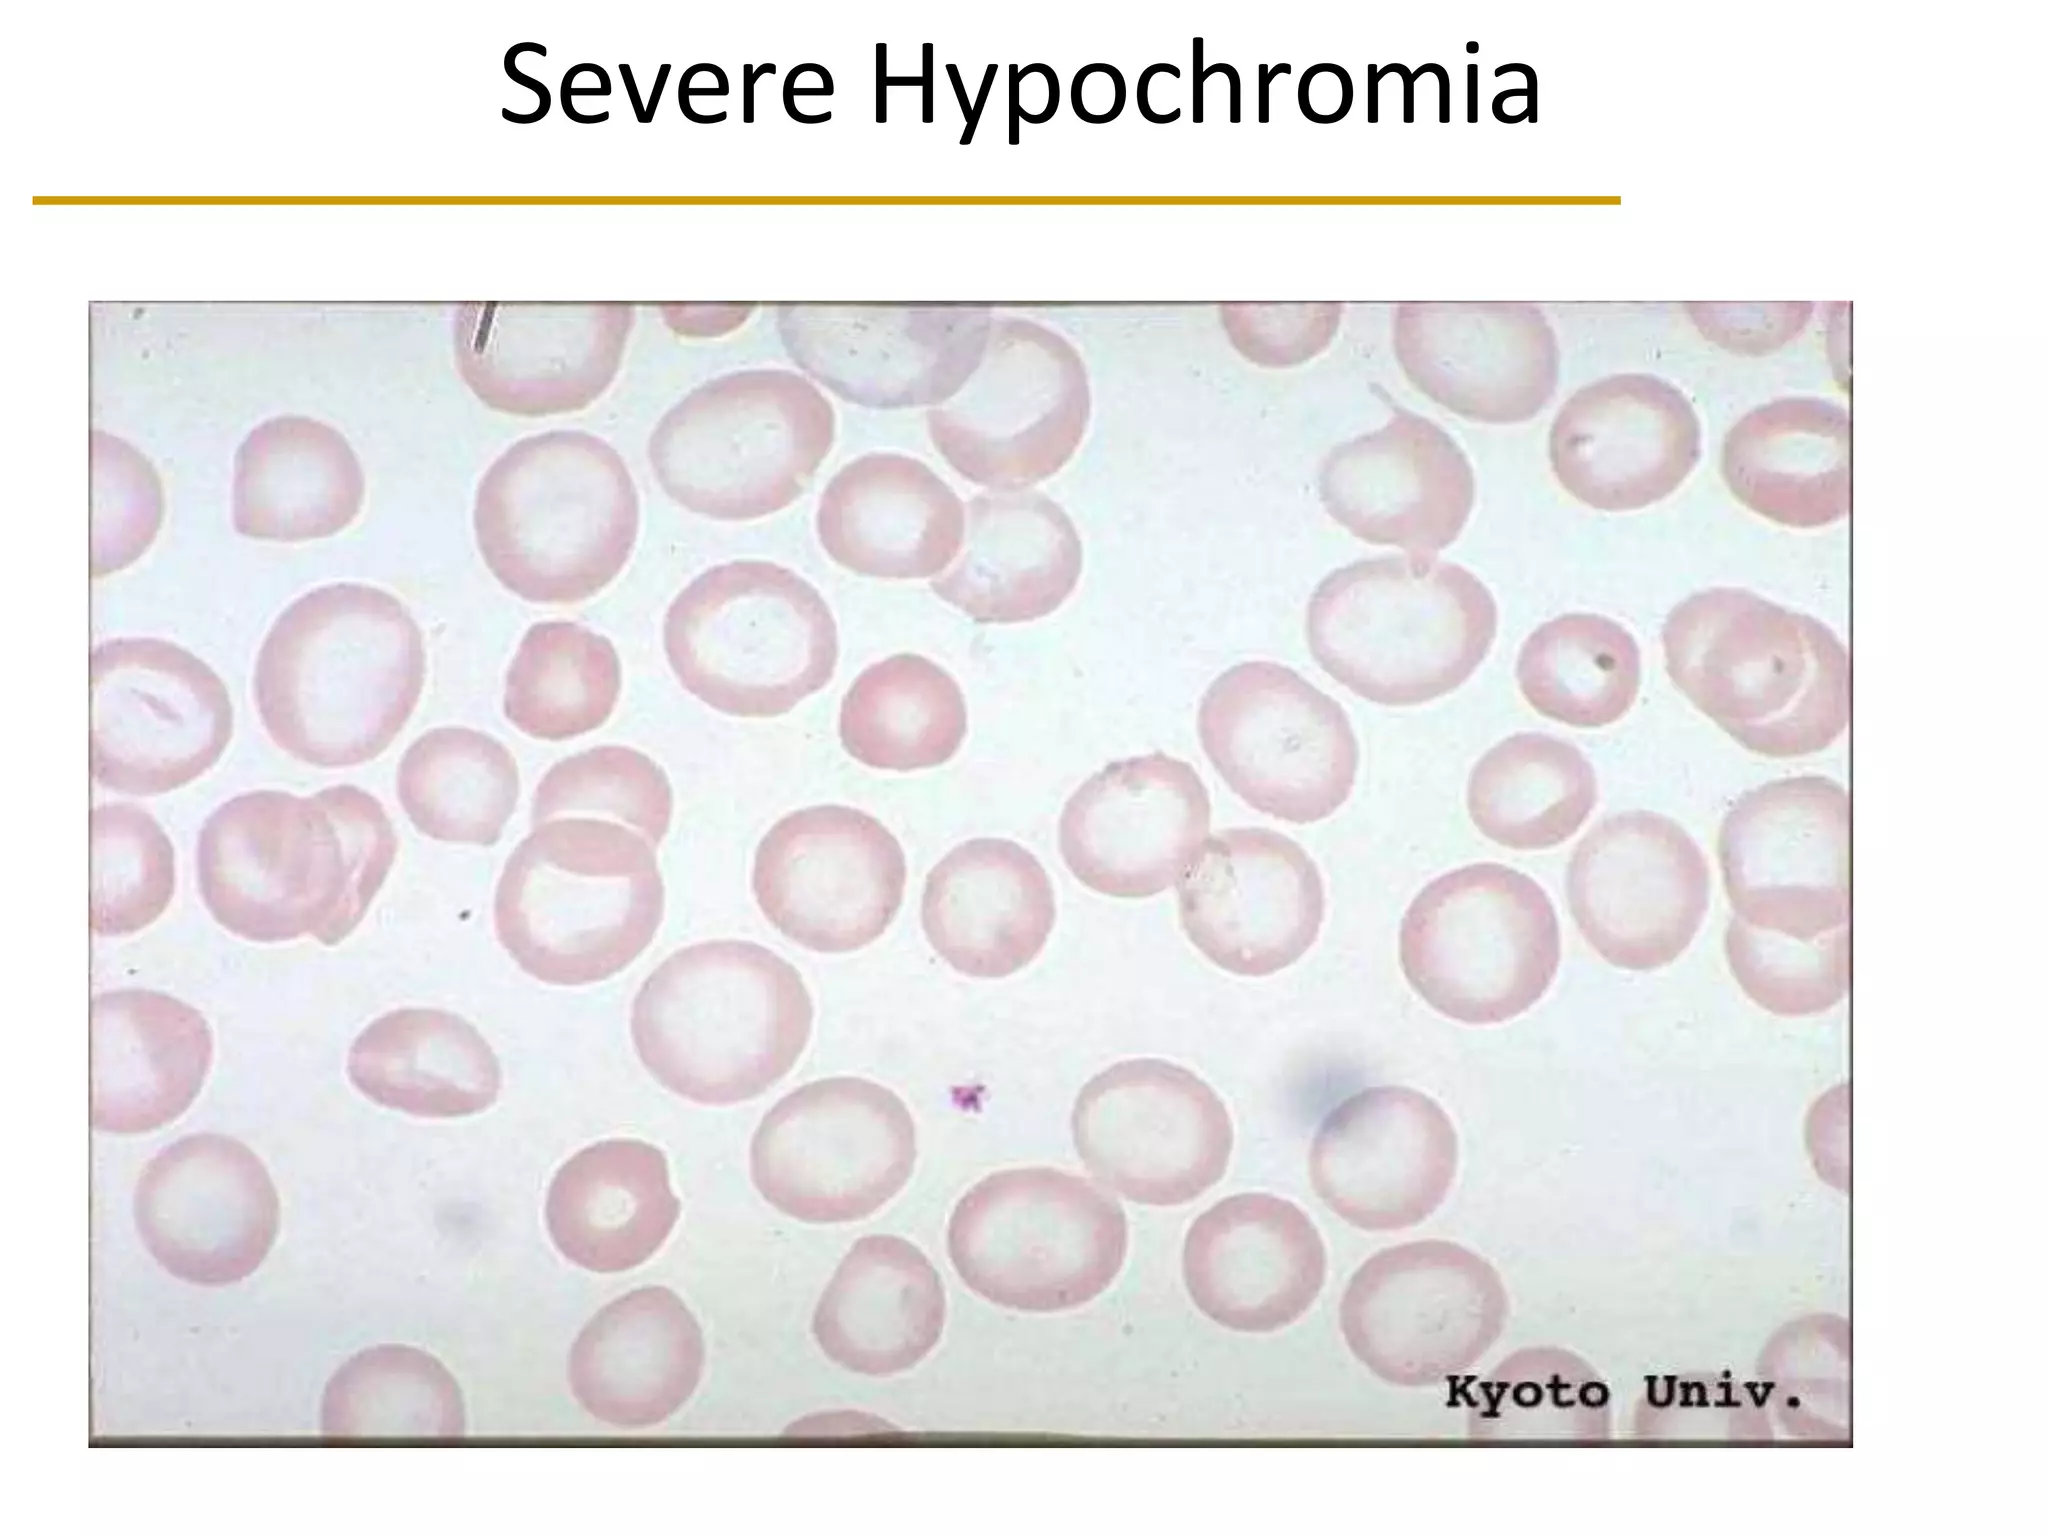
Severe Hypochromia
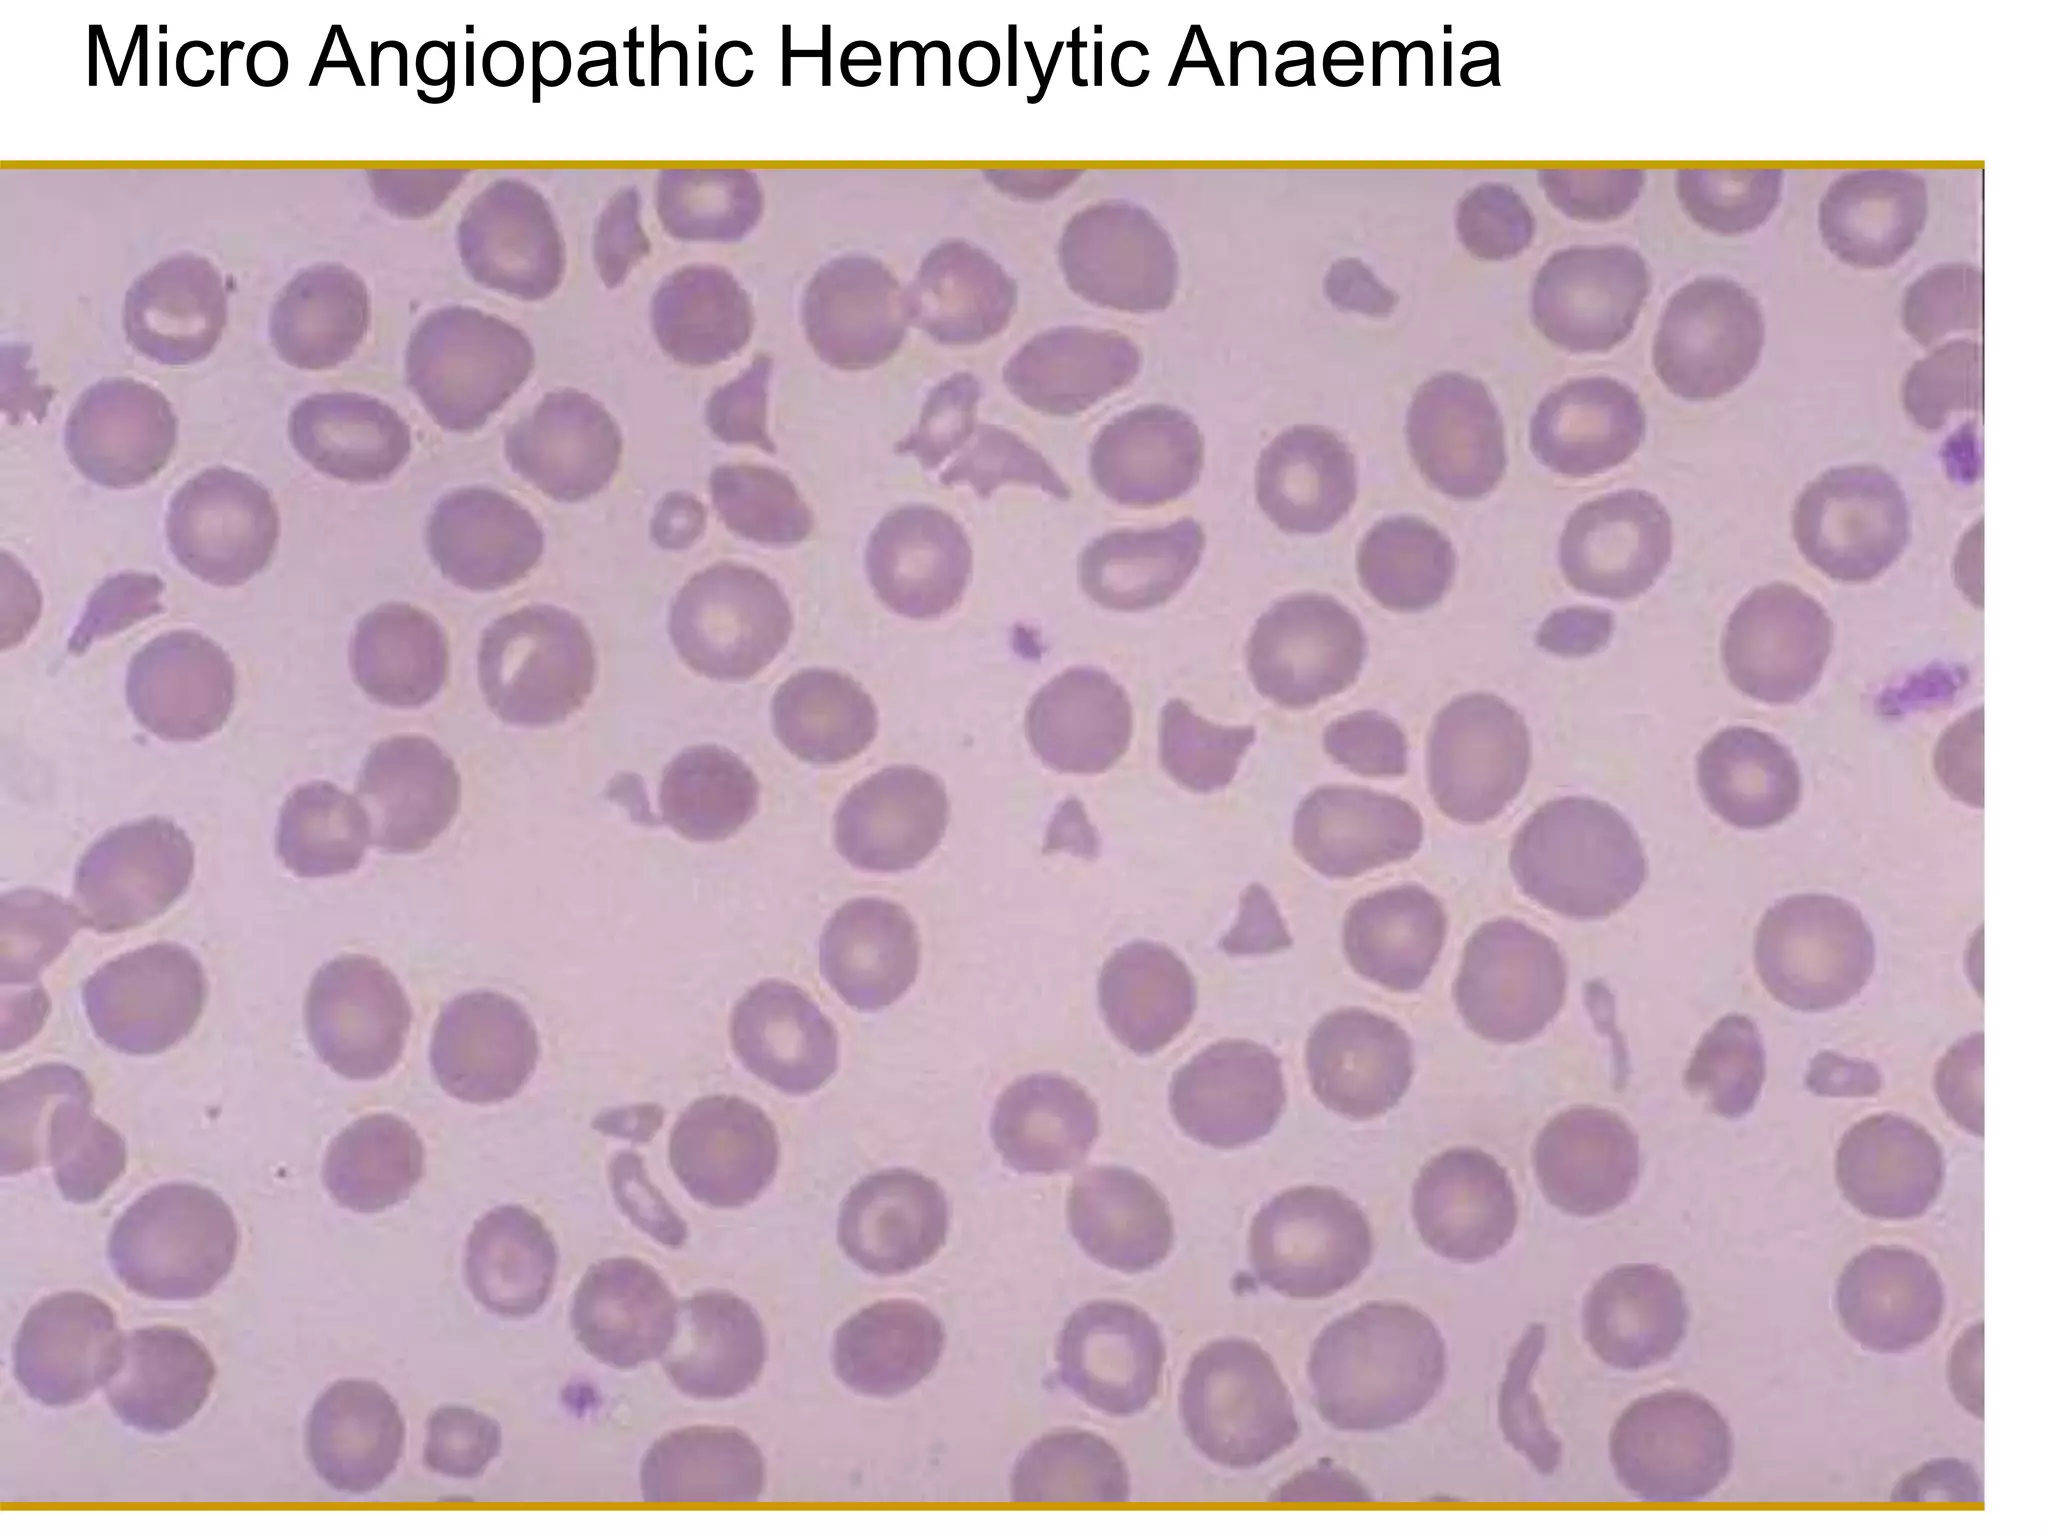
Micro Angiopathic Hemolytic Anaemia

This document provides an overview of approaches to evaluating and treating anemia. It defines anemia based on hemoglobin levels and describes the erythron, which is the machinery of red blood cell production influenced by factors like erythropoietin and hypoxia. Evaluation of anemia involves taking a medical history and performing a physical examination, as well as basic blood tests to measure red blood cell count, hemoglobin, hematocrit, and derived indices. Additional tests can provide clues to specific causes of anemia based on cell size and shape on peripheral smear and values of markers like ferritin, TIBC, and retic count. Causes of anemia are classified as microcytic, normocytic, or macrocy